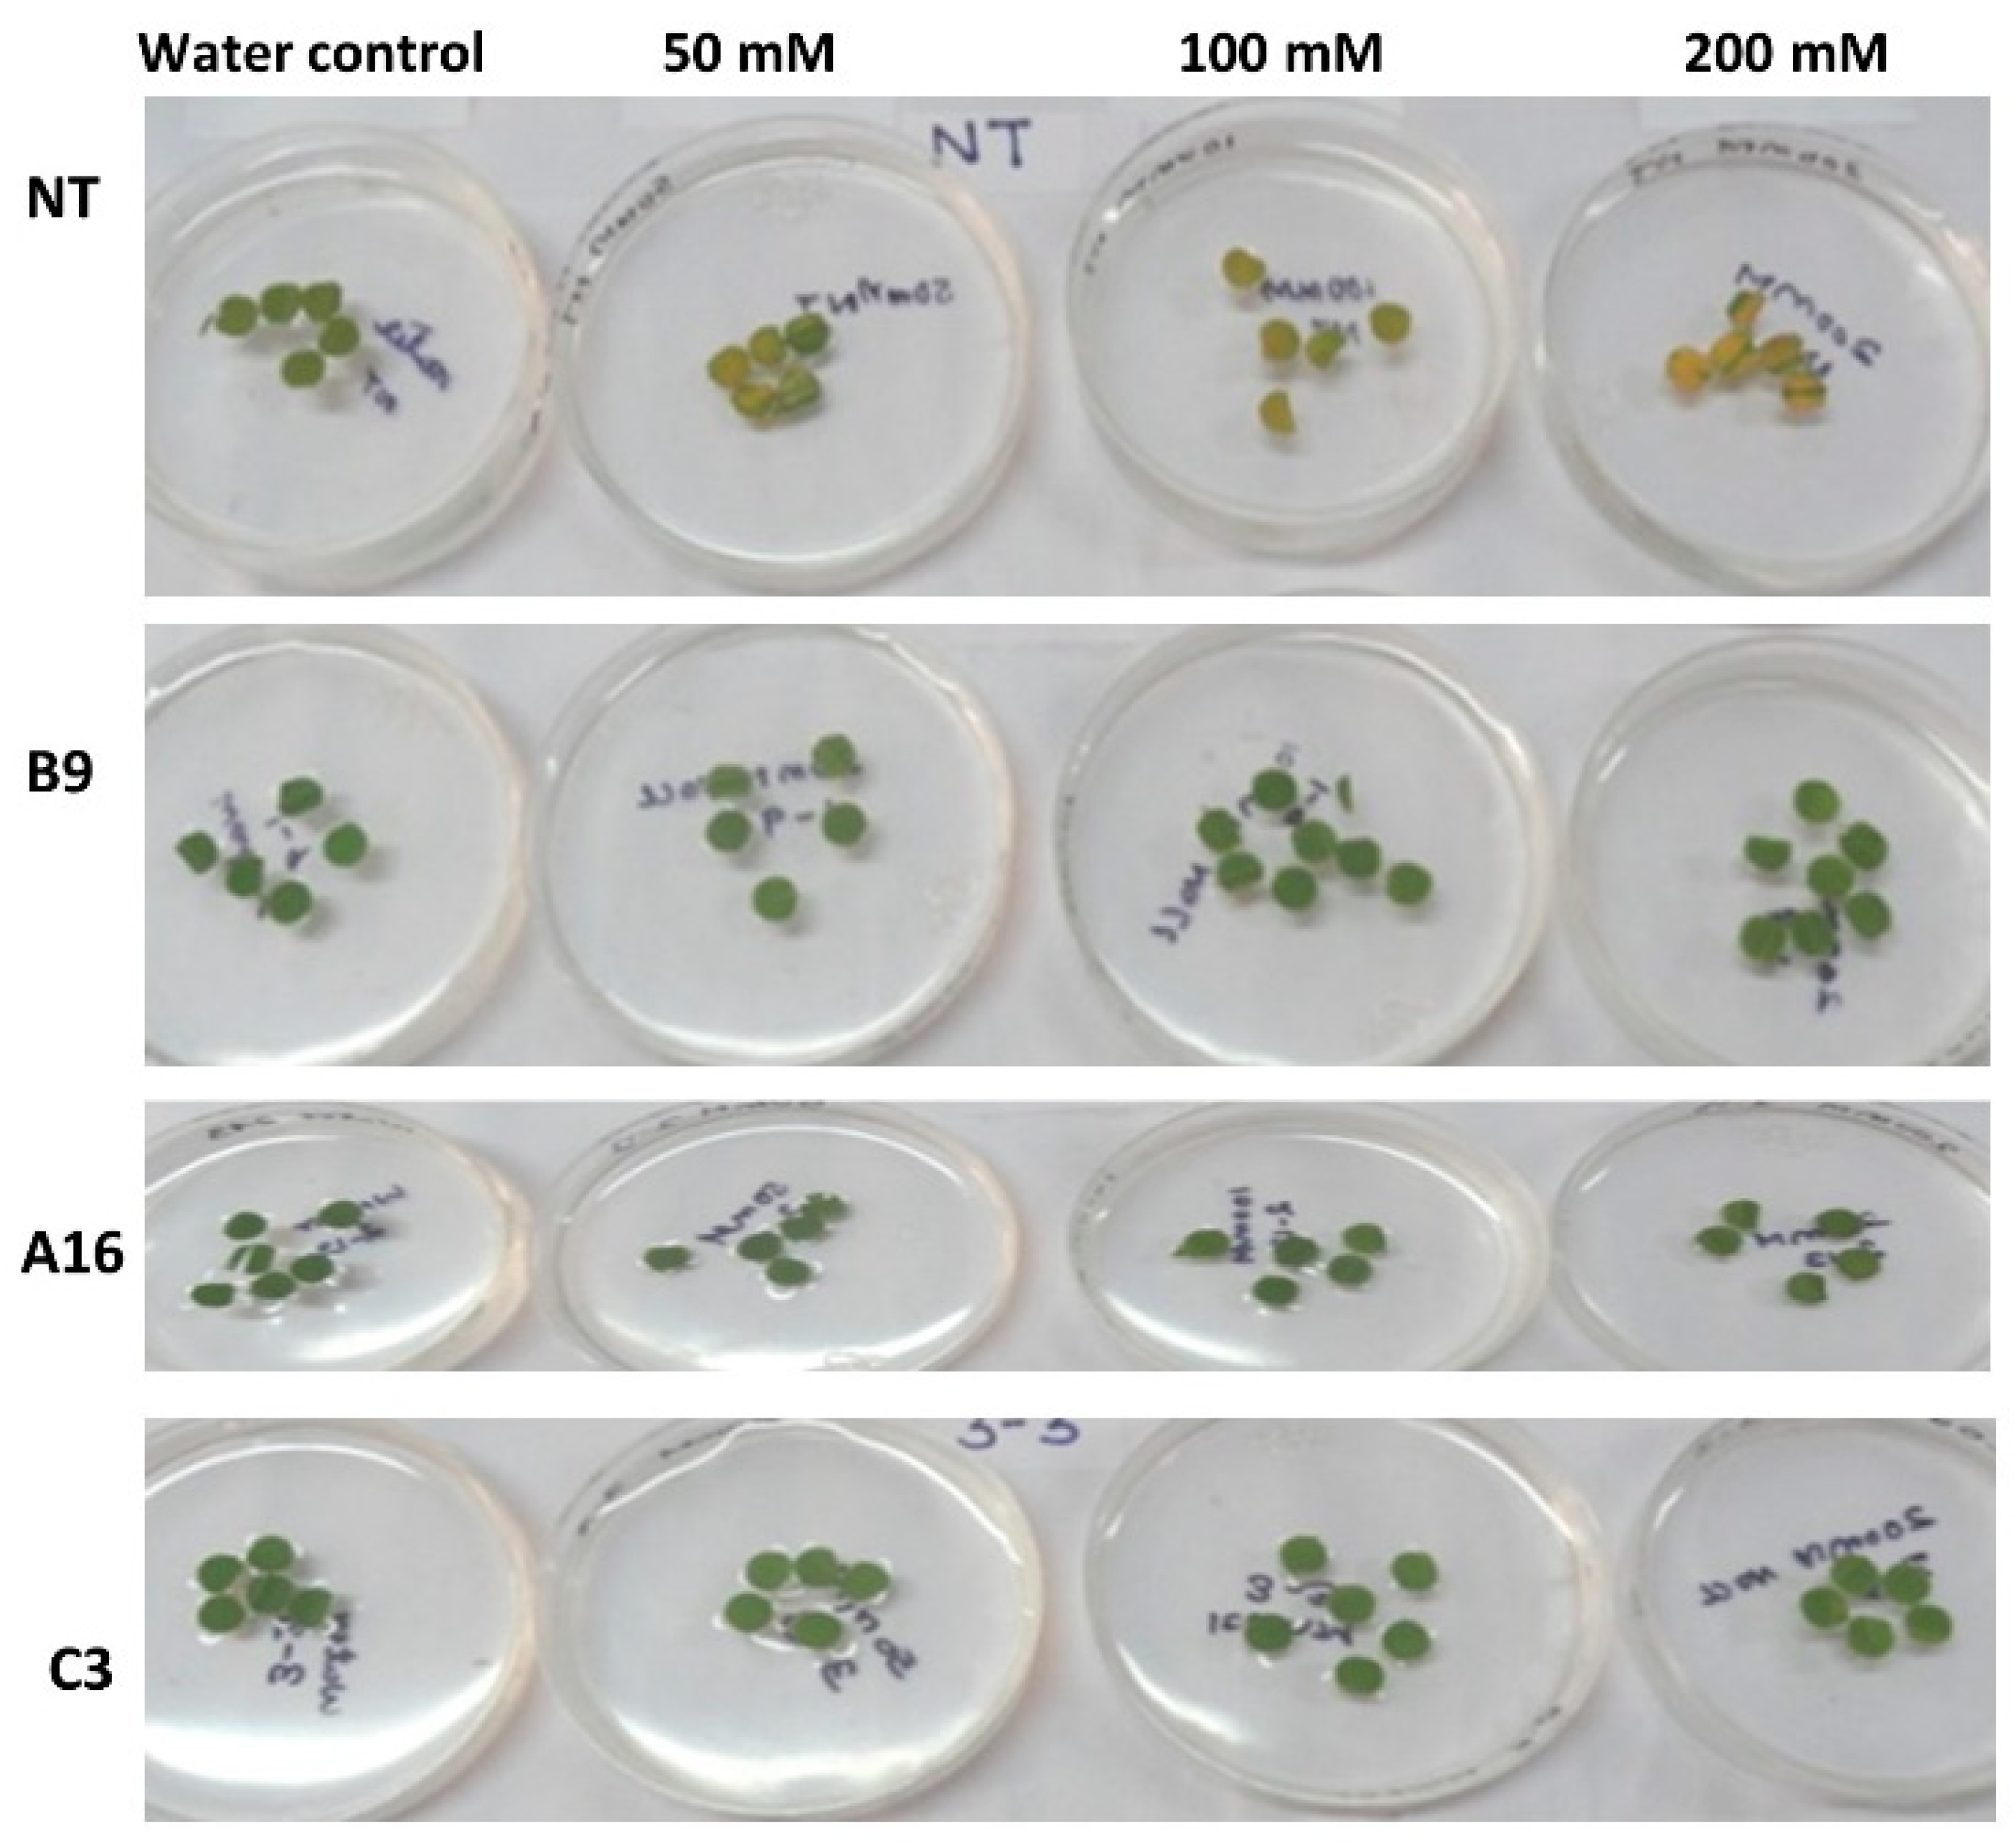
Agronomy 11 00159 g007 Agronomy 11 00159 g007

Controlled Over-Expression of AtDREB1A Enhances Tolerance against Drought and Salinity in Rice
Abstract
1. Introduction
2. Results
2.1. Development of Transgenic ADT 43 Lines and Molecular Analysis
2.2. Evaluation of Transgenic ADT 43 (T1 Generation) against Drought and Salinity
2.2.1. Drought Responses
Transgenic ADT 43 Lines Exhibited Enhanced Tolerance against Drought
Transgenic Lines Maintained Higher RWC and Lower Leaf Temperature
Transgenic Plants Exhibited Better Stomatal Control to Maintain Cellular Activities
Transgenic Plants Exhibited a Strong Induction of AtDREB1A during Drought Stress
2.2.2. Salinity Responses
Transgenic Plants Exhibited Higher Germination Percentage under Salinity Stress
Leaf Discs of Transgenic Plants Exhibited Slower Degradation of Chlorophyll
2.3. Evaluation of T2 and T3 Progenies of Line # A16 against Drought
2.4. Enhanced Salinity Tolerance of A16 (T2 and T3) Progenies during Vegetative Stage Stress
2.5. Agronomic Evaluation of Transgenic ADT 43 under Drought
3. Discussion
4. Materials and Methods
4.1. Construction of Plant Transformation Vector-Harboring AtDREB1A
4.2. Molecular Characterization of Putative Transgenic ADT43 Lines Engineered with AtDREB1A
PCR Analysis and Southern Hybridization Analysis
4.3. Evaluation of Transgenic ADT43 Lines Engineered with AtDREB1A against Drought
4.3.1. Measurement Soil and Leaf Water Status
4.3.2. Measurement of Leaf Temperature
4.3.3. Monitoring Drought-Responsive Stomatal Behavior in the Transgenic and Non-Transgenic ADT 43
4.4. Measuring Transcript Abundance of AtDREB1A through RT-PCR
4.5. Evaluation of Transgenic ADT43 Lines against Salinity
4.5.1. Germination Ability
4.5.2. Chlorophyll Retention Capacity under Salinity
4.5.3. Salinity Tolerance during the Vegetative Phase
4.6. Agronomic Evaluation of Transgenic Lines under Transgenic Screen House Conditions
4.7. Statistical Analyses
5. Conclusions
Author Contributions
Funding
Institutional Review Board Statement
Informed Consent Statement
Data Availability Statement
Acknowledgments
Conflicts of Interest
References
- Cooper, P.; Dimes, J.; Rao, K.; Shapiro, B.; Shiferaw, B.; Twomlow, S. Coping better with current climatic variability in the rain-fed farming systems of sub-Saharan Africa: An essential first step in adapting to future climate change? Agric. Ecosyst. Environ. 2008, 126, 24–35. [Google Scholar] [CrossRef]
- Iba, K. Acclimative response to temperature stress in higher plants: Approaches of gene engineering for temperature tolerance. Annu. Rev. Plant Biol. 2002, 53, 225–245. [Google Scholar] [CrossRef] [PubMed]
- Zhu, J.-K. Salt and drought stress signal transduction in plants. Annu. Rev. Plant Biol. 2002, 53, 247–273. [Google Scholar] [CrossRef] [PubMed]
- Yamaguchi-Shinozaki, K.; Shinozaki, K. Transcriptional regulatory networks in cellular responses and tolerance to dehydration and cold stresses. Annu. Rev. Plant Biol. 2006, 57, 781–803. [Google Scholar] [CrossRef]
- Hirayama, T.; Shinozaki, K. Research on plant abiotic stress responses in the post-genome era: Past, present and future. Plant J. 2010, 61, 1041–1052. [Google Scholar] [CrossRef]
- Matsukura, S.; Mizoi, J.; Yoshida, T.; Todaka, D.; Ito, Y.; Maruyama, K.; Shinozaki, K.; Yamaguchi-Shinozaki, K. Comprehensive analysis of rice DREB2-type genes that encode transcription factors involved in the expression of abiotic stress-responsive genes. Mol. Genet. Genom. 2010, 283, 185–196. [Google Scholar] [CrossRef]
- Lata, C.; Prasad, M. Role of DREBs in regulation of abiotic stress responses in plants. J. Exp. Bot. 2011, 62, 4731–4748. [Google Scholar] [CrossRef]
- Shinozaki, K.; Yamaguchi-Shinozaki, K. Gene networks involved in drought stress response and tolerance. J. Exp. Bot. 2007, 58, 221–227. [Google Scholar] [CrossRef]
- Golldack, D.; Lüking, I.; Yang, O. Plant tolerance to drought and salinity: Stress regulating transcription factors and their functional significance in the cellular transcriptional network. Plant Cell Rep. 2011, 30, 1383–1391. [Google Scholar] [CrossRef]
- Nakashima, K.; Yamaguchi-Shinozaki, K.; Shinozaki, K. The transcriptional regulatory network in the drought response and its crosstalk in abiotic stress responses including drought, cold, and heat. Front. Plant Sci. 2014, 5, 170. [Google Scholar] [CrossRef]
- Chen, L.; Song, Y.; Li, S.; Zhang, L.; Zou, C.; Yu, D. The role of WRKY transcription factors in plant abiotic stresses. Biochim. Biophys. Acta (BBA)-Gene Regul. Mech. 2012, 1819, 120–128. [Google Scholar] [CrossRef]
- Nuruzzaman, M.; Sharoni, A.M.; Kikuchi, S. Roles of NAC transcription factors in the regulation of biotic and abiotic stress responses in plants. Front. Microbiol. 2013, 4, 248. [Google Scholar] [PubMed]
- Guan, Y.; Meng, X.; Khanna, R.; LaMontagne, E.; Liu, Y.; Zhang, S. Phosphorylation of a WRKY transcription factor by MAPKs is required for pollen development and function in Arabidopsis. PLoS Genet 2014, 10, e1004384. [Google Scholar] [CrossRef] [PubMed]
- Dietz, K.-J.; Vogel, M.O.; Viehhauser, A. AP2/EREBP transcription factors are part of gene regulatory networks and integrate metabolic, hormonal and environmental signals in stress acclimation and retrograde signalling. Protoplasma 2010, 245, 3–14. [Google Scholar] [PubMed]
- Mizoi, J.; Shinozaki, K.; Yamaguchi-Shinozaki, K. AP2/ERF family transcription factors in plant abiotic stress responses. Biochim. Biophys. Acta (BBA)-Gene Regul. Mech. 2012, 1819, 86–96. [Google Scholar]
- Chandler, J.W. Class VIIIb APETALA2 ethylene response factors in plant development. Trends Plant Sci. 2018, 23, 151–162. [Google Scholar] [CrossRef] [PubMed]
- Hussain, S.; Iqbal, M.; Arif, M.; Amjad, M. Beyond osmolytes and transcription factors: Drought tolerance in plants via protective proteins and aquaporins. Biol. Plant. 2011, 55, 401–413. [Google Scholar]
- Xie, Z.; Nolan, T.M.; Jiang, H.; Yin, Y. AP2/ERF transcription factor regulatory networks in hormone and abiotic stress responses in Arabidopsis. Front. Plant Sci. 2019, 10, 228. [Google Scholar]
- Yamaguchi-Shinozaki, K.; Shinozaki, K. Arabidopsis DNA encoding two desiccation-responsive rd29 genes. Plant Physiol. 1993, 101, 1119. [Google Scholar] [CrossRef]
- Stockinger, E.J.; Gilmour, S.J.; Thomashow, M.F. Arabidopsis thaliana CBF1 encodes an AP2 domain-containing transcriptional activator that binds to the C-repeat/DRE, a cis-acting DNA regulatory element that stimulates transcription in response to low temperature and water deficit. Proce. Natl. Acad. Sci. USA 1997, 94, 1035–1040. [Google Scholar]
- Liu, Q.; Kasuga, M.; Sakuma, Y.; Abe, H.; Miura, S.; Yamaguchi-Shinozaki, K.; Shinozaki, K. Two transcription factors, DREB1 and DREB2, with an EREBP/AP2 DNA binding domain separate two cellular signal transduction pathways in drought-and low-temperature-responsive gene expression, respectively, in Arabidopsis. Plant Cell 1998, 10, 1391–1406. [Google Scholar] [PubMed]
- Yamaguchi-Shinozaki, K.; Shinozaki, K. Organization of cis-acting regulatory elements in osmotic-and cold-stress-responsive promoters. Trends Plant Sci. 2005, 10, 88–94. [Google Scholar] [CrossRef] [PubMed]
- Dubouzet, J.G.; Sakuma, Y.; Ito, Y.; Kasuga, M.; Dubouzet, E.G.; Miura, S.; Seki, M.; Shinozaki, K.; Yamaguchi-Shinozaki, K. OsDREB genes in rice, Oryza sativa L., encode transcription activators that function in drought-, high-salt-and cold-responsive gene expression. Plant J. 2003, 33, 751–763. [Google Scholar] [CrossRef] [PubMed]
- Gilmour, S.J.; Sebolt, A.M.; Salazar, M.P.; Everard, J.D.; Thomashow, M.F. Overexpression of the Arabidopsis CBF3transcriptional activator mimics multiple biochemical changes associated with cold acclimation. Plant Physiol. 2000, 124, 1854–1865. [Google Scholar] [CrossRef] [PubMed]
- Maruyama, K.; Sakuma, Y.; Kasuga, M.; Ito, Y.; Seki, M.; Goda, H.; Shimada, Y.; Yoshida, S.; Shinozaki, K.; Yamaguchi-Shinozaki, K. Identification of cold-inducible downstream genes of the Arabidopsis DREB1A/CBF3 transcriptional factor using two microarray systems. Plant J. 2004, 38, 982–993. [Google Scholar] [CrossRef] [PubMed]
- Wang, Q.; Guan, Y.; Wu, Y.; Chen, H.; Chen, F.; Chu, C. Overexpression of a rice OsDREB1F gene increases salt, drought, and low temperature tolerance in both Arabidopsis and rice. Plant Mol. Biol. 2008, 67, 589–602. [Google Scholar] [CrossRef] [PubMed]
- Cong, L.; Zheng, H.-C.; Zhang, Y.-X.; Chai, T.-Y. Arabidopsis DREB1A confers high salinity tolerance and regulates the expression of GA dioxygenases in Tobacco. Plant Sci. 2008, 174, 156–164. [Google Scholar] [CrossRef]
- Hong, B.; Tong, Z.; Ma, N.; Li, J.; Kasuga, M.; Yamaguchi-Shinozaki, K.; Gao, J. Heterologous expression of the AtDREB1A gene in chrysanthemum increases drought and salt stress tolerance. Sci. China Ser. C Life Sci. 2006, 49, 436–445. [Google Scholar] [CrossRef]
- Kasuga, M.; Liu, Q.; Miura, S.; Yamaguchi-Shinozaki, K.; Shinozaki, K. Improving plant drought, salt, and freezing tolerance by gene transfer of a single stress-inducible transcription factor. Nat. Biotechnol. 1999, 17, 287–291. [Google Scholar] [CrossRef]
- Ganguly, M.; Roychoudhury, A.; Sarkar, S.N.; Sengupta, D.N.; Datta, S.K.; Datta, K. Inducibility of three salinity/abscisic acid-regulated promoters in transgenic rice with gusA reporter gene. Plant Cell Rep. 2011, 30, 1617. [Google Scholar] [CrossRef]
- Acosta-Motos, J.R.; Rothwell, S.A.; Massam, M.J.; Albacete, A.; Zhang, H.; Dodd, I.C. Alternate wetting and drying irrigation increases water and phosphorus use efficiency independent of substrate phosphorus status of vegetative rice plants. Plant Physiol. Biochem. 2020, 155, 914–926. [Google Scholar] [CrossRef] [PubMed]
- Rahman, H.; Ramanathan, V.; Nallathambi, J.; Duraialagaraja, S.; Muthurajan, R. Over-expression of a NAC 67 transcription factor from finger millet (Eleusine coracana L.) confers tolerance against salinity and drought stress in rice. BMC Biotechnol. 2016, 16, 35. [Google Scholar] [CrossRef] [PubMed]
- Valarmathi, M.; Sasikala, R.; Rahman, H.; Jagadeeshselvam, N.; Kambale, R.; Raveendran, M. Development of salinity tolerant version of a popular rice variety improved white ponni through marker assisted back cross breeding. Plant Physiol. Rep. 2019, 24, 262–271. [Google Scholar] [CrossRef]
- Jaglo-Ottosen, K.R.; Gilmour, S.J.; Zarka, D.G.; Schabenberger, O.; Thomashow, M.F. Arabidopsis CBF1 overexpression induces COR genes and enhances freezing tolerance. Science 1998, 280, 104–106. [Google Scholar] [CrossRef] [PubMed]
- Ramanjulu, S.; Bartels, D. Drought-and desiccation-induced modulation of gene expression in plants. Plant Cell Environ. 2002, 25, 141–151. [Google Scholar] [CrossRef] [PubMed]
- Xin, L.; Yun, L. Transcription Factors Re1ated to Plant Stress-To1erance. Chin. Agric. Sci. Bull. 2006, 4, 61–65. [Google Scholar]
- Seki, M.; Narusaka, M.; Abe, H.; Kasuga, M.; Yamaguchi-Shinozaki, K.; Carninci, P.; Hayashizaki, Y.; Shinozaki, K. Monitoring the expression pattern of 1300 Arabidopsis genes under drought and cold stresses by using a full-length cDNA microarray. Plant Cell 2001, 13, 61–72. [Google Scholar]
- Kasuga, M.; Miura, S.; Shinozaki, K.; Yamaguchi-Shinozaki, K. A combination of the Arabidopsis DREB1A gene and stress-inducible rd29A promoter improved drought-and low-temperature stress tolerance in tobacco by gene transfer. Plant Cell Physiol. 2004, 45, 346–350. [Google Scholar] [CrossRef]
- Khan, S.; Anwar, S.; Yu, S.; Sun, M.; Yang, Z.; Gao, Z.-q. Development of drought-tolerant transgenic wheat: Achievements and limitations. Int. J. Mol. Sci. 2019, 20, 3350. [Google Scholar] [CrossRef]
- Jia, X.; Li, Y.; Qi, E.; Ma, S.; Hu, X.; Wen, G.; Wang, Y.; Li, J.; Zhang, X.; Wang, H. Overexpression of the Arabidopsis DREB1A gene enhances potato drought-resistance. Russ. J. Plant Physiol. 2016, 63, 523–531. [Google Scholar] [CrossRef]
- Datta, K.; Baisakh, N.; Ganguly, M.; Krishnan, S.; Yamaguchi Shinozaki, K.; Datta, S.K. Overexpression of Arabidopsis and rice stress genes’ inducible transcription factor confers drought and salinity tolerance to rice. Plant Biotechnol. J. 2012, 10, 579–586. [Google Scholar] [CrossRef] [PubMed]
- Ravikumar, G.; Manimaran, P.; Voleti, S.; Subrahmanyam, D.; Sundaram, R.; Bansal, K.; Viraktamath, B.; Balachandran, S. Stress-inducible expression of AtDREB1A transcription factor greatly improves drought stress tolerance in transgenic indica rice. Transgenic Res. 2014, 23, 421–439. [Google Scholar] [CrossRef] [PubMed]
- Siddique, M.; Hamid, A.; Islam, M. Drought stress effects on water relations of wheat. Bot. Bull. Acad. Sin. 2000, 41, 35–39. [Google Scholar]
- Bhatnagar-Mathur, P.; Vadez, V.; Sharma, K.K. Transgenic approaches for abiotic stress tolerance in plants: Retrospect and prospects. Plant Cell Rep. 2008, 27, 411–424. [Google Scholar] [CrossRef] [PubMed]
- Gerakis, P.; Guerrero, F.; Williams, W. Growth, water relations and nutrition of three grassland annuals as affected by drought. J. Appl. Ecol. 1975, 12, 125–135. [Google Scholar] [CrossRef]
- Bhatnagar-Mathur, P.; Devi, M.J.; Reddy, D.S.; Lavanya, M.; Vadez, V.; Serraj, R.; Yamaguchi-Shinozaki, K.; Sharma, K.K. Stress-inducible expression of At DREB1A in transgenic peanut (Arachis hypogaea L.) increases transpiration efficiency under water-limiting conditions. Plant Cell Rep. 2007, 26, 2071–2082. [Google Scholar] [CrossRef]
- Ito, Y.; Katsura, K.; Maruyama, K.; Taji, T.; Kobayashi, M.; Seki, M.; Shinozaki, K.; Yamaguchi-Shinozaki, K. Functional analysis of rice DREB1/CBF-type transcription factors involved in cold-responsive gene expression in transgenic rice. Plant Cell Physiol. 2006, 47, 141–153. [Google Scholar] [CrossRef]
- Lin, R.-C.; Park, H.-J.; Wang, H.-Y. Role of Arabidopsis RAP2.4 in regulating light-and ethylene-mediated developmental processes and drought stress tolerance. Mol. Plant 2008, 1, 42–57. [Google Scholar] [CrossRef]
- Acosta-Motos, J.R.; Ortuño, M.F.; Bernal-Vicente, A.; Diaz-Vivancos, P.; Sanchez-Blanco, M.J.; Hernandez, J.A. Plant responses to salt stress: Adaptive mechanisms. Agronomy 2017, 7, 18. [Google Scholar] [CrossRef]
- Umezawa, T.; Fujita, M.; Fujita, Y.; Yamaguchi-Shinozaki, K.; Shinozaki, K. Engineering drought tolerance in plants: Discovering and tailoring genes to unlock the future. Curr. Opin. Biotechnol. 2006, 17, 113–122. [Google Scholar] [CrossRef]
- Nakashima, K.; Ito, Y.; Yamaguchi-Shinozaki, K. Transcriptional regulatory networks in response to abiotic stresses in Arabidopsis and grasses. Plant Physiol. 2009, 149, 88–95. [Google Scholar] [CrossRef] [PubMed]
- Pardo, J.M. Biotechnology of water and salinity stress tolerance. Curr. Opin. Biotechnol. 2010, 21, 185–196. [Google Scholar] [CrossRef]
- Yang, S.; Vanderbeld, B.; Wan, J.; Huang, Y. Narrowing down the targets: Towards successful genetic engineering of drought-tolerant crops. Mol. Plant 2010, 3, 469–490. [Google Scholar] [CrossRef] [PubMed]
- Islam, M.A.; Du, H.; Ning, J.; Ye, H.; Xiong, L. Characterization of Glossy1-homologous genes in rice involved in leaf wax accumulation and drought resistance. Plant Mol. Biol. 2009, 70, 443–456. [Google Scholar]
- Oh, S.-J.; Kim, Y.S.; Kwon, C.-W.; Park, H.K.; Jeong, J.S.; Kim, J.-K. Overexpression of the transcription factor AP37 in rice improves grain yield under drought conditions. Plant Physiol. 2009, 150, 1368–1379. [Google Scholar] [CrossRef]
- Xiao, B.-Z.; Chen, X.; Xiang, C.-B.; Tang, N.; Zhang, Q.-F.; Xiong, L.-Z. Evaluation of seven function-known candidate genes for their effects on improving drought resistance of transgenic rice under field conditions. Mol. Plant 2009, 2, 73–83. [Google Scholar] [CrossRef] [PubMed]
- Du, H.; Wang, N.; Cui, F.; Li, X.; Xiao, J.; Xiong, L. Characterization of the β-carotene hydroxylase gene DSM2 conferring drought and oxidative stress resistance by increasing xanthophylls and abscisic acid synthesis in rice. Plant Physiol. 2010, 154, 1304–1318. [Google Scholar] [PubMed]
- Jeong, J.S.; Kim, Y.S.; Baek, K.H.; Jung, H.; Ha, S.-H.; Do Choi, Y.; Kim, M.; Reuzeau, C.; Kim, J.-K. Root-specific expression of OsNAC10 improves drought tolerance and grain yield in rice under field drought conditions. Plant Physiol. 2010, 153, 185–197. [Google Scholar] [CrossRef]
- Kumar, A.; Bernier, J.; Verulkar, S.; Lafitte, H.; Atlin, G. Breeding for drought tolerance: Direct selection for yield, response to selection and use of drought-tolerant donors in upland and lowland-adapted populations. Field Crops Res. 2008, 107, 221–231. [Google Scholar] [CrossRef]
- Pellegrineschi, A.; Reynolds, M.; Pacheco, M.; Brito, R.M.; Almeraya, R.; Yamaguchi-Shinozaki, K.; Hoisington, D. Stress-induced expression in wheat of the Arabidopsis thaliana DREB1A gene delays water stress symptoms under greenhouse conditions. Genome 2004, 47, 493–500. [Google Scholar]
- Hiei, Y.; Ohta, S.; Komari, T.; Kumashiro, T. Efficient transformation of rice (Oryza sativa L.) mediated by Agrobacterium and sequence analysis of the boundaries of the T-DNA. Plant J. 1994, 6, 271–282. [Google Scholar] [CrossRef] [PubMed]
- Lin, Y.J.; Zhang, Q. Optimising the tissue culture conditions for high efficiency transformation of indica rice. Plant Cell Rep. 2005, 23, 540–547. [Google Scholar] [CrossRef] [PubMed]
- Ausubel, F.; Brent, R.; Kingston, R.; Moore, D.; Seidman, J.; Smith, J.; Struhl, K. Current Protocols in Molecular Biology; John Wiley & Sons Inc.: Hoboken, NJ, USA, 2003; Volume 1. [Google Scholar]
- Ausubel, F.M.; Brent, R.; Kingston, R.E.; Moore, D.; Seidman, J.; Smith, J.T.; Struhl, K. Short Protocols in Molecular Biology; John Wiley and Sons: Hoboken, NJ, USA, 1992. [Google Scholar]
- Sambrook, H. Molecular Cloning: A Laboratory Manual; Cold Spring Harbor Laboratory Press: Cold Spring Harbor, NY, USA, 1989. [Google Scholar]
- Barrs, H.; Weatherley, P. A re-examination of the relative turgidity technique for estimating water deficits in leaves. Aust. J. Biol. Sci. 1962, 15, 413–428. [Google Scholar] [CrossRef]
- Puértolas, J.; Larsen, E.K.; Davies, W.J.; Dodd, I.C. Applying ‘drought’to potted plants by maintaining suboptimal soil moisture improves plant water relations. J. Exp. Bot. 2017, 68, 2413–2424. [Google Scholar] [CrossRef] [PubMed]
- Livak, K.J.; Schmittgen, T.D. Analysis of relative gene expression data using real-time quantitative PCR and the 2−ΔΔCT method. Methods 2001, 25, 402–408. [Google Scholar] [CrossRef]
- Bewley, J.D.; Black, M. Physiology and Biochemistry of Seeds in Relation to Germination. V. 2. Viability, Dormancy, and Environmental Control; Springer: Heidelberg, Germany, 1982. [Google Scholar]

| Traits | NT | A16 | p-Value | LSD at 5% | ||
|---|---|---|---|---|---|---|
| Control | Stress | Control | Stress | |||
| Plant height (cm) | 96.1 ± 2.0 A | 82.7 ± 2.13 B | 97.9 ± 1.40 A | 83.95 ± 1.12 B | 0.001 | 6.428 |
| No. of tillers per plant | 20.7 ± 1.10 A | 20.4 ± 2.03 A | 19.6 ± 1.35 A | 17.2 ± 1.09 C | 0.01 | 2.456 |
| No. of panicles per plant | 20.5 ± 1.04 A | 19 ± 1.85 A | 19.6 ± 1.38 A | 15.5 ± 0.75 B | 0.001 | 3.125 |
| Plant Biomass (g) | 72.89 ± 7.5 A | 32.45 ± 3.1 C | 70.16 ± 2.9 A B | 44.51 ± 2.66 BC | <0.0001 | 20.998 |
| Panicle Length (cm) | 20.87 ± 0.40 B | 16.97 ± 0.35 C | 21.99 ± 0.22 A | 22.155 ± 0.34 A | <0.0001 | 1.575 |
| Number of spikelets per panicle | 199.5 ± 10.8 A | 154.5 ± 11.30 B | 201.9 ± 16.90 A | 195.78 ± 7.0 A | 0.0032 | 46.313 |
| No. of filled spikelets | 176.5 ± 11.3 A | 87.89 ± 8.1 B | 177.66 ± 15.60 A | 134.35 ± 6.70 A | <0.0001 | 39.731 |
| No. of sterile spikelets | 25.28 ± 1.2 B | 64.10 ± 2.10 A | 24.55 ± 1.30 B | 59.50 ± 3.50 A | 0.0001 | 22.204 |
| Spikelet sterility (%) | 13.02 ± 1.10 C | 41.25 ± 4.1 A | 14.50 ± 1.20 C | 30.88 ± 2.4 B | <0.0001 | 12.383 |
| Grain yield per plant (g) | 44.24 ± 4.5 A | 9.42 ± 3.1 B | 43.73 ± 1.7 A | 19.18 ± 1.2 B | <0.0001 | 12.583 |
| 100 Grain Weight (g) | 1.6 ± 0.03 B | 1.16 ± 0.02 D | 1.78 ± 0.02 A | 1.36 ± 0.02 C | <0.0001 | 0.1428 |
Publisher’s Note: MDPI stays neutral with regard to jurisdictional claims in published maps and institutional affiliations. |
© 2021 by the authors. Licensee MDPI, Basel, Switzerland. This article is an open access article distributed under the terms and conditions of the Creative Commons Attribution (CC BY) license (http://creativecommons.org/licenses/by/4.0/).
Share and Cite
Muthurajan, R.; Ramanathan, V.; Bansilal Shillak, A.; Madhuri Pralhad, S.; Shankarrao, C.N.; Rahman, H.; Kambale, R.; Nallathambi, J.; Tamilselvan, S.; Madasamy, P. Controlled Over-Expression of AtDREB1A Enhances Tolerance against Drought and Salinity in Rice. Agronomy 2021, 11, 159. https://doi.org/10.3390/agronomy11010159
Muthurajan R, Ramanathan V, Bansilal Shillak A, Madhuri Pralhad S, Shankarrao CN, Rahman H, Kambale R, Nallathambi J, Tamilselvan S, Madasamy P. Controlled Over-Expression of AtDREB1A Enhances Tolerance against Drought and Salinity in Rice. Agronomy. 2021; 11(1):159. https://doi.org/10.3390/agronomy11010159
Chicago/Turabian StyleMuthurajan, Raveendran, Valarmathi Ramanathan, Abhijeet Bansilal Shillak, Suryawanshi Madhuri Pralhad, Chavan Neha Shankarrao, Hifzur Rahman, Rohit Kambale, Jagadeeshselvam Nallathambi, Sudha Tamilselvan, and Parani Madasamy. 2021. "Controlled Over-Expression of AtDREB1A Enhances Tolerance against Drought and Salinity in Rice" Agronomy 11, no. 1: 159. https://doi.org/10.3390/agronomy11010159
APA StyleMuthurajan, R., Ramanathan, V., Bansilal Shillak, A., Madhuri Pralhad, S., Shankarrao, C. N., Rahman, H., Kambale, R., Nallathambi, J., Tamilselvan, S., & Madasamy, P. (2021). Controlled Over-Expression of AtDREB1A Enhances Tolerance against Drought and Salinity in Rice. Agronomy, 11(1), 159. https://doi.org/10.3390/agronomy11010159

